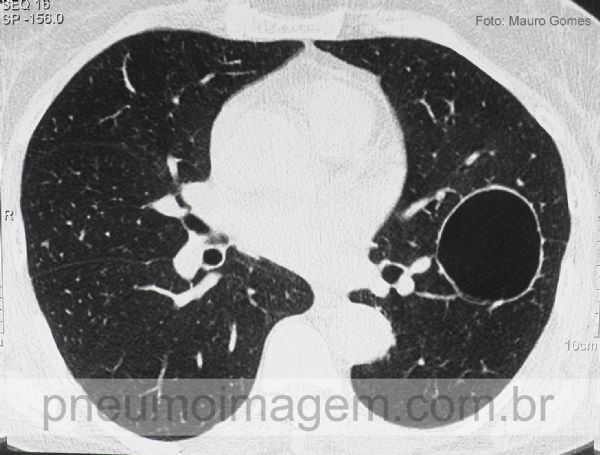

.jpg)
Cisto broncogênico faz parte de um espectro de anomalias congênitas do pulmão que inclui seqüestro pulmonar, malformação adenomatóide cística congênita e
hiperinsuflação lobar congênita. Observe a fina linha circular que delimita área de maior transparência (seta) e poderia ser confundida com uma bolha.
Chaves:
bronchogenic cyst (thin circular line delimiting the area of transparency (arrow) and could be confused with a bubble emphysema).
.jpg)
Detalhe da radiografia em PA mostrando a fina linha circular que delimita área de maior transparência. Os cistos broncogênicos decorrem da brotação anormal da árvore brônquica primitiva, o que ocorre entre os dias 26 e 40 de gestação. O diagnóstico diferencial deve ser feito com bolha e, quando possui nível líquido, com abscesso pulmonar.
Chaves: nível hidraéreo; hidroaéreo.
.jpg)
Ao perfil, observe a seta mostrando toda a tênue linha que delimita a circunferência do cisto. Os cistos broncogênicos são revestidos por epitélio colunar ciliado ou epitélio cubóide e estão rodeados por tecidos semelhantes aos do brônquio normal, incluindo cartilagem, músculo liso, tecido elástico e glândulas mucosas.
.jpg)
Detalhe da incidência em perfil demonstrando a tênue linha que delimita a circunferência do cisto.
Corte de tomografia de alta resolução com a imagem cística intraparenquimatosa sem conteúdo no seu interior (cisto broncogênico intraparenquimatoso).
Na sua maioria, os cistos estão localizados no mediastino ao longo da árvore traqueobrônquica, mas também podem ser encontrados no parênquima pulmonar ou abaixo do diafragma. Quando os cistos são intrapulmonares, o diagnóstico é mais difícil.
Chaves: intraparenchymal bronchogenic cyst.

Corte tomográfico na mesma altura da imagem anterior após o tratamento cirúrgico da lesão.
Chaves: post-surgical treatment of the injury.
DEIXE SEU COMENTÁRIO